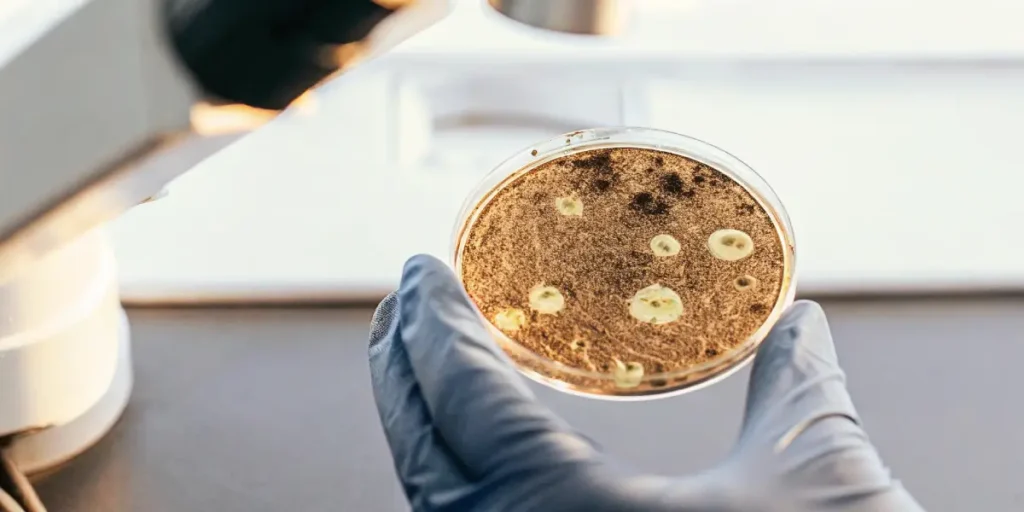
A gloved hand examining a petri dish with microorganisms under a microscope.

Optimizing Soil Microbes for Cannabis
Optimizing soil microbes for cannabis is key to achieving robust plant growth and bountiful harvests. These tiny organisms, though invisible to the naked eye, play a vital role in breaking down organic matter and enhancing nutrient availability. A thriving microbial community contributes to healthier cannabis plants.
Soil microbes, including bacteria, fungi, and protozoa, interact with cannabis roots to create a beneficial environment. This interaction helps in improving cannabis yield by facilitating the absorption of nutrients. For first-time seed buyers, knowing the importance of these microbes can make a significant difference in your cultivation journey.
Recommended Strains
Grizzly Purple Auto
| | THC | 9% - 13% (Low) |
| | Type | Autoflowering |
| | Yield | Low |
| | Phenotype | 80% Indica / 20% Sativa |
Grizzly Purple Kush
| | THC | 15% - 20% (Medium) |
| | Type | Feminized |
| | Yield | High |
| | Phenotype | 70% Indica / 30% Sativa |
Experienced growers know the power of enhancing soil microbes for cannabis growth. By ensuring a balanced microbial environment, you can prevent many common plant issues. Implementing microbial soil amendments for cannabis cultivation can lead to healthier plants and more potent buds.
The Importance of Soil Microbial Balance for Healthy Cannabis Plants
Maintaining a soil microbial balance for healthy cannabis plants is crucial. An imbalance can lead to nutrient lockout, where plants are unable to absorb the nutrients they need. This can stunt growth and reduce yield. Balanced soil microbes ensure that nutrients are readily available to your cannabis plants when needed.
Using organic soil microbe solutions for cannabis can help maintain this balance. Organic solutions often contain beneficial bacteria and fungi that work symbiotically with your plants. These solutions are environmentally friendly and sustain the natural ecosystem within your soil.
Besides to using organic solutions, testing your soil regularly can help maintain a balanced microbial environment. Soil testing provides valuable insights into nutrient levels and pH, allowing you to make informed decisions about amendments. By monitoring these factors, you can tailor your practices to ensure optimal conditions for soil microbes.
Another effective strategy is to minimize soil disturbance. Tilling can disrupt microbial habitats, reducing their population and effectiveness. No-till gardening practices allow microbes to thrive undisturbed, promoting a healthy soil structure and enhancing soil microbes for cannabis growth.
Promos & Deals
Practical Steps for Enhancing Soil Microbes for Cannabis Growth
Enhancing soil microbes for cannabis growth involves a few practical steps. First, consider using compost tea. This brew of compost and water is rich in beneficial microbes. Apply it to your soil to boost microbial activity. It’s an easy, DIY method that brings noticeable results.
Another step is rotating between different cannabis strains. Different strains can alter soil microbe populations. For example, growing Grizzly Purple Kush after a cycle of Black D.O.G. might encourage a diverse microbial community, further enhancing soil health.
Additionally, incorporating cover crops can be beneficial. Cover crops, such as clover or alfalfa, improve soil structure and provide organic matter that feeds soil microbes. This practice can sustain a vibrant microbial community, which in turn supports robust cannabis growth.
Mulching is another practical approach to optimizing soil microbes for cannabis. By covering the soil with organic material like straw or leaves, you create a habitat that retains moisture and feeds microbes as it decomposes. This natural layer supports microbial activity and contributes to a fertile growing environment.

Using Microbial Soil Amendments for Cannabis Cultivation
Microbial soil amendments for cannabis cultivation are supplements that increase the microbial population in your soil. These amendments can be found in various forms, such as powders, liquids, or granules, and often contain a mix of beneficial bacteria and fungi.
When applying these amendments, it’s important to follow the instructions carefully. Overuse can lead to an imbalance, negating the benefits. Regular application as per the manufacturer’s guidelines ensures a steady increase in beneficial microbes.
Microbial soil amendments not only boost the microbial community but also improve soil fertility. They enhance nutrient cycling and increase the availability of essential elements to cannabis plants. This results in improved plant health and potentially higher yields.
Moreover, some microbial amendments contain mycorrhizal fungi, which form a symbiotic relationship with plant roots. This association extends the root system, allowing better nutrient and water absorption. Incorporating these amendments can be a game-changer in enhancing soil microbes for cannabis growth.
Improving Cannabis Yield with Soil Microbes
Improving cannabis yield with soil microbes is achievable by fostering a thriving microbial environment. Healthy microbes break down organic material, converting it into nutrients that cannabis plants can absorb. This process is essential for creating a nutrient-rich soil environment.
To further boost yields, ensure your soil remains moist but not waterlogged. Overwatering can harm microbial life, so aim for a balanced watering schedule. Mulching is another technique that helps retain moisture and provides an additional food source for microbes.
To optimize soil microbes for cannabis, consider integrating organic fertilizers with microbial amendments. Organic fertilizers provide nutrients in forms that microbes can easily process, leading to enhanced plant growth and yield. This combination supports a sustainable and productive cultivation system.
Regular observation and adaptation are key to improving cannabis yield with soil microbes. Pay attention to plant health and growth patterns, adjusting your microbial management techniques as necessary. This proactive approach ensures that your cannabis plants receive the maximum benefits from their microbial partners.

FAQs
How do soil microbes benefit cannabis plants?
Soil microbes benefit cannabis plants by breaking down organic matter into nutrients that plants can easily absorb. This process enhances nutrient availability, promoting healthier and more vigorous growth. A healthy microbial population helps in disease prevention, reducing the need for chemical interventions.
Microbes also improve soil structure, allowing better root penetration and water retention. This means cannabis plants can access water and nutrients more effectively, leading to improved resilience against drought and other stresses. Overall, optimizing soil microbes for cannabis leads to stronger, more productive plants.
Additionally, soil microbes contribute to building soil organic matter, which is crucial for long-term soil health. This improved soil quality fosters a resilient growing environment, supporting successive cannabis cultivation cycles without degrading the soil.
The biological diversity that soil microbes provide also helps suppress harmful pathogens and pests. By maintaining a balanced microbial ecosystem, cannabis plants are better protected against potential threats, reducing the reliance on chemical pesticides.
What are the signs of an imbalanced microbial environment in cannabis cultivation?
An imbalanced microbial environment often manifests as nutrient deficiencies, despite adequate fertilization. You may notice yellowing leaves, stunted growth, or poor bud development. These signs indicate that the cannabis plants are not absorbing nutrients efficiently due to microbial imbalances.
Soil compaction and poor drainage can also be signs of microbial imbalance. Healthy microbes help maintain good soil structure. If you experience these issues, consider adding microbial soil amendments for cannabis cultivation to restore balance and promote plant health.
Another indicator of imbalance is the presence of excessive pests or diseases. A healthy microbial population naturally suppresses harmful organisms, so an increase in such issues could suggest a disrupted microbial community. Addressing this with appropriate amendments can restore balance.
Inconsistent growth patterns across different areas of your grow space can also point to microbial imbalance. Variations in plant health and vigor may reflect localized deficiencies in microbial activity, necessitating targeted interventions to harmonize conditions.
Can I use chemical fertilizers with organic soil microbe solutions for cannabis?
While it’s possible to use chemical fertilizers alongside organic soil microbe solutions for cannabis, it’s not always recommended. Chemical fertilizers can harm beneficial microbes, reducing their effectiveness. If you choose to use them, do so sparingly and monitor plant response closely.
Opting for organic fertilizers is often better when aiming to enhance soil microbes for cannabis growth. They are more compatible with microbial life, supporting a thriving ecosystem and leading to a more sustainable cultivation practice.
In cases where chemical fertilizers are used, consider supplementing with microbial inoculants to counteract any negative effects. These products can replenish and support the microbial community, ensuring the soil remains conducive to healthy cannabis growth.
Ultimately, the goal is to maintain a delicate balance that supports both plant nutrition and microbial health. By prioritizing organic and natural inputs, you can achieve optimal results with minimal disruption to the soil ecosystem.
How often should I apply microbial soil amendments?
The frequency of applying microbial soil amendments depends on the product and your specific growing conditions. Generally, a monthly application is sufficient to maintain a healthy microbial population. Always follow the manufacturer’s instructions for best results.
Regular applications help sustain a balanced soil environment, but over-application can lead to imbalances. Keep an eye on your plants’ health and soil conditions to adjust the frequency as needed, ensuring optimal microbial activity.
Seasonal changes may also influence the application schedule. During periods of active growth, more frequent applications might be beneficial, while dormant phases may require less intervention. Adapting to these cycles can enhance soil microbes for cannabis growth.
Furthermore, integrating microbial amendments into your routine soil management practices can contribute to a stable and productive growing environment. This proactive approach ensures that your cannabis plants consistently benefit from a robust microbial community.
What are some recommended cannabis strains for optimizing soil microbes?
Some cannabis strains are particularly well-suited for optimizing soil microbes due to their robust growth and adaptability. Grizzly Purple Kush is known for its resilience and ability to thrive in diverse soil conditions, making it a great choice for microbial optimization.
Another recommended strain is Black D.O.G., which benefits from a rich microbial environment and offers impressive yields. Sour Diesel is also a favorite among growers looking to enhance soil microbes for cannabis growth, known for its robust performance in organic settings.
Besides to these, strains like Blue Dream and Northern Lights are also acclaimed for their compatibility with microbial-rich environments. Their vigorous growth patterns and adaptability make them ideal candidates for optimizing soil microbes for cannabis cultivation.
Experimenting with different strains and observing their interactions with soil microbes can provide valuable insights. This practice not only enhances your growing skills but also contributes to a more dynamic and productive cultivation process.














